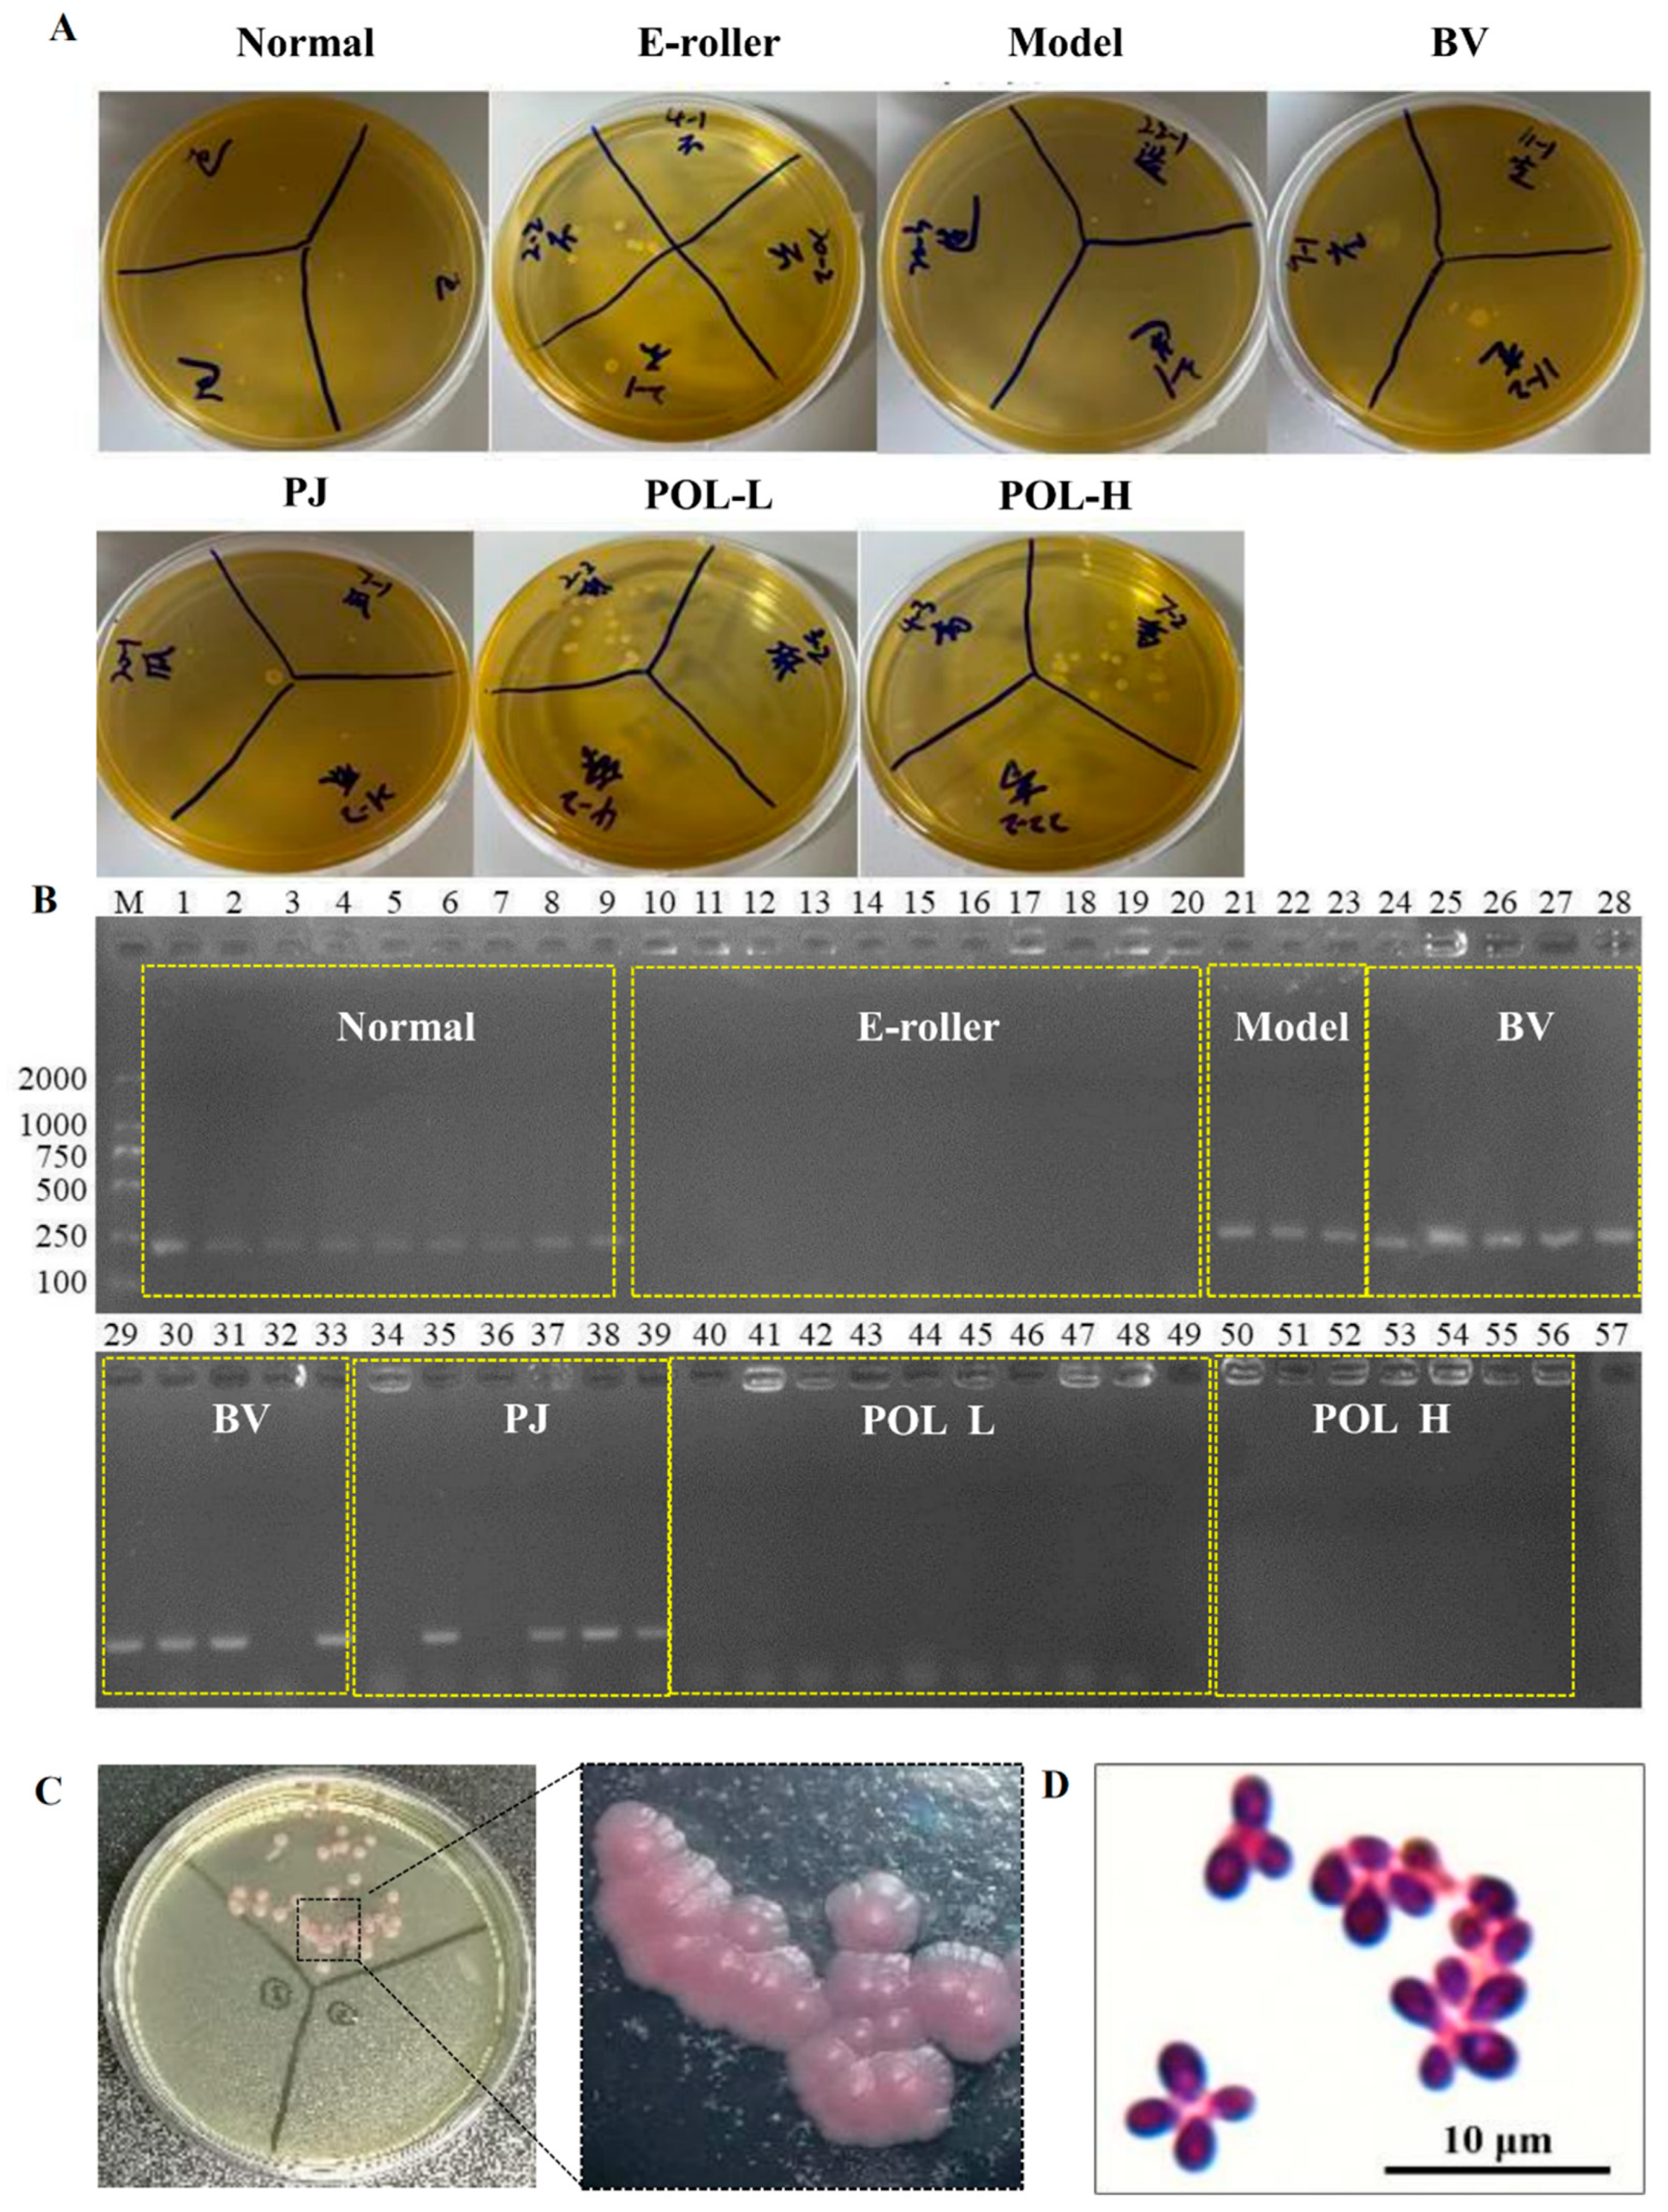
Molecules 27 07520 g004 Molecules 27 07520 g004

Polygalaxanthone III, an Active Ingredient in Polygala japonica Houtt., Repaired Malassezia-Stimulated Skin Injury via STAT3 Phosphorylated Activation
Abstract
1. Introduction
2. Results
2.1. Growth Curve and Characteristics of the Extracts of M. furfur
2.2. Malassezia furfur-Infected C57BL/6 Mouse Skin Resulted in Skin Rupture
2.3. Polygalaxanthone III Festinating Repaired the Malassezia furfur-Infected Skin Injury
2.4. Histologic Examination and Masson Staining
2.5. Identification and Microscopic Examination of Malassezia furfur Colonies in Wound Skin
2.6. POL Reduced the Amount of Lipid Droplets Secreted by M. furfur-Stimulated HaCaT Cells
2.7. Western Blot Analysis of Mice Skin Tissues
3. Discussion
3.1. The Excess of M. furfur Damaged Skin Barrier Function
3.2. POL Attenuated Lipid Droplet Formation in M. furfur-Stimulated HaCaT Cells
3.3. POL Repaired Malassezia furfur-Stimulated Skin Injury via STAT3 Phosphorylated Activation
4. Materials and Methods
4.1. Chemicals and Reagents
4.2. Strains
4.3. Cells
4.4. Animals
4.5. Growth Curve and Biochemical Analyses of Malassezia furfur
4.6. Methods for LC-MS/MS Analysis
4.7. Animal Model and Experimental Protocol
4.8. Identification of Malassezia furfur
4.9. Western Blotting
4.10. Lipid Droplets Formed in HaCaT Cells
4.11. Statistical Analysis
5. Conclusions
Author Contributions
Funding
Institutional Review Board Statement
Informed Consent Statement
Data Availability Statement
Acknowledgments
Conflicts of Interest
References
- Cafarchia, C.; Gasser, R.B.; Figueredo, L.A.; Latrofa, M.S.; Otranto, D. Advances in the identification of Malassezia. Mol. Cell. Probes 2011, 25, 1–7. [Google Scholar] [CrossRef]
- Grice, E.A.; Dawson, T.L., Jr. Host-microbe interactions: Malassezia and human skin. Curr. Opin. Microbiol. 2017, 40, 81–87. [Google Scholar] [CrossRef] [PubMed]
- Theelen, B.; Cafarchia, C.; Gaitanis, G.; Bassukas, I.D.; Boekhout, T.; Dawson, T.L., Jr. Malassezia ecology, pathophysiology, and treatment. Med. Mycol. 2018, 56 (Suppl. 1), S10–S25. [Google Scholar] [CrossRef]
- Jo, J.H.; Deming, C.; Kennedy, E.A.; Conlan, S.; Polley, E.C.; Ng, W.I.; Segre, J.A.; Kong, H.H.; NISC Comparative Sequencing Program. Diverse Human Skin Fungal Communities in Children Converge in Adulthood. J. Investig. Dermatol. 2016, 136, 2356–2363. [Google Scholar] [CrossRef] [PubMed]
- Vest, B.E.; Krauland, K. Malassezia furfur; StatPearls Publishing: Treasure Island, FL, USA, 2021. [Google Scholar]
- Chebil, W.; Haouas, N.; Eskes, E.; Vandecruys, P.; Belgacem, S.; Belhadj Ali, H.; Babba, H.; Van Dijck, P. In Vitro Assessment of Azole and Amphotericin B Susceptibilities of Malassezia spp. Isolated from Healthy and Lesioned Skin. J. Fungi 2022, 8, 959. [Google Scholar] [CrossRef]
- Campoy, S.; Adrio, J.L. Antifungals. Biochem. Pharmacol. 2017, 133, 86–96. [Google Scholar] [CrossRef]
- Revie, N.M.; Iyer, K.R.; Robbins, N.; Cowen, L.E. Antifungal drug resistance: Evolution, mechanisms and impact. Curr. Opin. Microbiol. 2018, 45, 70–76. [Google Scholar] [CrossRef] [PubMed]
- Sanglard, D. Emerging Threats in Antifungal-Resistant Fungal Pathogens. Front. Med. 2016, 3, 11. [Google Scholar] [CrossRef] [PubMed]
- Laokor, N.; Juntachai, W. Exploring the antifungal activity and mechanism of action of Zingiberaceae rhizome extracts against Malassezia furfur. J. Ethnopharmacol. 2021, 279, 114354. [Google Scholar] [CrossRef]
- Romald, P.N.; Kindo, A.J.; Mahalakshmi, V.; Umadevi, U. Epidemiological pattern of Malassezia, its phenotypic identification and antifungal susceptibility profile to azoles by broth microdilution method. Indian J. Med. Microbiol. 2020, 38, 351–356. [Google Scholar] [CrossRef]
- Wikramanayake, T.C.; Borda, L.J.; Miteva, M.; Paus, R. Seborrheic dermatitis-Looking beyond Malassezia. Exp. Dermatol. 2019, 28, 991–1001. [Google Scholar] [CrossRef] [PubMed]
- Juntachai, W.; Oura, T.; Murayama, S.Y.; Kajiwara, S. The lipolytic enzymes activities of Malassezia species. Med. Mycol. 2009, 47, 477–484. [Google Scholar] [CrossRef] [PubMed]
- Grimshaw, S.G.; Smith, A.M.; Arnold, D.S.; Xu, E.; Hoptroff, M.; Murphy, B. The diversity and abundance of fungi and bacteria on the healthy and dandruff affected human scalp. PLoS ONE 2019, 14, e0225796. [Google Scholar] [CrossRef] [PubMed]
- Lacaille-Dubois, M.A.; Delaude, C.; Mitaine-Offer, A.C. A review on the phytopharmacological studies of the genus Polygala. J. Ethnopharmacol. 2020, 249, 112417. [Google Scholar] [CrossRef]
- Wu, Y.; Fu, H.; Yang, X.; Leng, F.; Huang, Y.; Deng, H.; Xiang, Q.; Zhang, S. Polygalaxanthone III downregulates inflammation in the lipopolysaccharide-stimulated RAW264.7 macrophages: A quantibody array analysis. J. Pharmacol. Sci. 2021, 147, 184–191. [Google Scholar] [CrossRef] [PubMed]
- Sivasankar, C.; Gayathri, S.; Bhaskar, J.P.; Krishnan, V.; Pandian, S.K. Evaluation of selected Indian medicinal plants for antagonistic potential against Malassezia spp. and the synergistic effect of embelin in combination with ketoconazole. Microb. Pathog. 2017, 110, 66–72. [Google Scholar] [CrossRef]
- Lu, S.; Wang, Q.; Li, G.; Sun, S.; Guo, Y.; Kuang, H. The treatment of rheumatoid arthritis using Chinese medicinal plants: From pharmacology to potential molecular mechanisms. J. Ethnopharmacol. 2015, 176, 177–206. [Google Scholar] [CrossRef]
- Wu, G.; Zhao, H.; Li, C.; Rajapakse, M.P.; Wong, W.C.; Xu, J.; Saunders, C.W.; Reeder, N.L.; Reilman, R.A.; Scheynius, A.; et al. Genus-Wide Comparative Genomics of Malassezia Delineates Its Phylogeny, Physiology, and Niche Adaptation on Human Skin. PLoS Genet. 2015, 11, e1005614. [Google Scholar] [CrossRef]
- Cabanes, F.J. Malassezia pachydermatis: To be, or not to be lipid-dependent. Rev. Iberoam. Micol. 2020, 37, 3–4. [Google Scholar] [CrossRef]
- Liu, H.; Archer, N.K.; Dillen, C.A.; Wang, Y.; Ashbaugh, A.G.; Ortines, R.V.; Kao, T.; Lee, S.K.; Cai, S.S.; Miller, R.J.; et al. Staphylococcus aureus Epicutaneous Exposure Drives Skin Inflammation via IL-36-Mediated T Cell Responses. Cell Host Microbe 2017, 22, 653–666.e5. [Google Scholar] [CrossRef]
- Gao, Z.; Perez-Perez, G.I.; Chen, Y.; Blaser, M.J. Quantitation of major human cutaneous bacterial and fungal populations. J. Clin. Microbiol. 2010, 48, 3575–3581. [Google Scholar] [CrossRef] [PubMed]
- Vijaya Chandra, S.H.; Srinivas, R.; Dawson, T.L., Jr.; Common, J.E. Cutaneous Malassezia: Commensal, Pathogen, or Protector? Front. Cell. Infect. Microbiol. 2020, 10, 614446. [Google Scholar] [CrossRef] [PubMed]
- Sparber, F.; LeibundGut-Landmann, S. Host Responses to Malassezia spp. in the Mammalian Skin. Front. Immunol. 2017, 8, 1614. [Google Scholar] [CrossRef] [PubMed]
- Vallhov, H.; Johansson, C.; Veerman, R.E.; Scheynius, A. Extracellular Vesicles Released From the Skin Commensal Yeast Malassezia sympodialis Activate Human Primary Keratinocytes. Front. Cell. Infect. Microbiol. 2020, 10, 6. [Google Scholar] [CrossRef] [PubMed]
- Benveniste, E.N.; Liu, Y.; McFarland, B.C.; Qin, H. Involvement of the janus kinase/signal transducer and activator of transcription signaling pathway in multiple sclerosis and the animal model of experimental autoimmune encephalomyelitis. J. Interf. Cytokine Res. 2014, 34, 577–588. [Google Scholar] [CrossRef]
- Kopalli, S.R.; Annamneedi, V.P.; Koppula, S. Potential Natural Biomolecules Targeting JAK/STAT/SOCS Signaling in the Management of Atopic Dermatitis. Molecules 2022, 27, 4660. [Google Scholar] [CrossRef]
- Ha, Y.; Lee, W.H.; Kim, J.K.; Jeon, H.K.; Lee, J.; Kim, Y.J. Polyopes affinis Suppressed IFN-gamma- and TNF-alpha-Induced Inflammation in Human Keratinocytes via Down-Regulation of the NF-kappaB and STAT1 Pathways. Molecules 2022, 27, 1836. [Google Scholar] [CrossRef]
- Hu, X.; Li, J.; Fu, M.; Zhao, X.; Wang, W. The JAK/STAT signaling pathway: From bench to clinic. Signal Transduct. Target. Ther. 2021, 6, 402. [Google Scholar] [CrossRef]
- Casanova, J.L.; Holland, S.M.; Notarangelo, L.D. Inborn errors of human JAKs and STATs. Immunity 2012, 36, 515–528. [Google Scholar] [CrossRef]
- Hao, D.; Wen, X.; Liu, L.; Wang, L.; Zhou, X.; Li, Y.; Zeng, X.; He, G.; Jiang, X. Sanshool improves UVB-induced skin photodamage by targeting JAK2/STAT3-dependent autophagy. Cell Death Dis. 2019, 10, 19. [Google Scholar] [CrossRef]
- Jaskiewicz, A.; Domoradzki, T.; Pajak, B. Targeting the JAK2/STAT3 Pathway-Can We Compare It to the Two Faces of the God Janus? Int. J. Mol. Sci. 2020, 21, 8261. [Google Scholar] [CrossRef] [PubMed]
- Harden, J.L.; Krueger, J.G.; Bowcock, A.M. The immunogenetics of Psoriasis: A comprehensive review. J. Autoimmun. 2015, 64, 66–73. [Google Scholar] [CrossRef] [PubMed]
- Furue, M. Regulation of Skin Barrier Function via Competition between AHR Axis versus IL-13/IL-4JAKSTAT6/STAT3 Axis: Pathogenic and Therapeutic Implications in Atopic Dermatitis. J. Clin. Med. 2020, 9, 3741. [Google Scholar] [CrossRef]
- Fernandez-Gallego, N.; Sanchez-Madrid, F.; Cibrian, D. Role of AHR Ligands in Skin Homeostasis and Cutaneous Inflammation. Cells 2021, 10, 3176. [Google Scholar] [CrossRef]
- Sparber, F.; Ruchti, F.; LeibundGut-Landmann, S. Host Immunity to Malassezia in Health and Disease. Front. Cell. Infect. Microbiol. 2020, 10, 198. [Google Scholar] [CrossRef] [PubMed]
- Gendrisch, F.; Esser, P.R.; Schempp, C.M.; Wolfle, U. Luteolin as a modulator of skin aging and inflammation. Biofactors 2021, 47, 170–180. [Google Scholar] [CrossRef]
- Simon, L.S.; Taylor, P.C.; Choy, E.H.; Sebba, A.; Quebe, A.; Knopp, K.L.; Porreca, F. The Jak/STAT pathway: A focus on pain in rheumatoid arthritis. Semin. Arthritis Rheum. 2021, 51, 278–284. [Google Scholar] [CrossRef]
- Liu, Q.; Li, D.; Wang, A.; Dong, Z.; Yin, S.; Zhang, Q.; Ye, Y.; Li, L.; Lin, L. Nitric oxide inhibitory xanthones from the pericarps of Garcinia mangostana. Phytochemistry 2016, 131, 115–123. [Google Scholar] [CrossRef]
- Syam, S.; Bustamam, A.; Abdullah, R.; Sukari, M.A.; Hashim, N.M.; Mohan, S.; Looi, C.Y.; Wong, W.F.; Yahayu, M.A.; Abdelwahab, S.I. beta Mangostin suppress LPS-induced inflammatory response in RAW 264.7 macrophages in vitro and carrageenan-induced peritonitis in vivo. J. Ethnopharmacol. 2014, 153, 435–445. [Google Scholar] [CrossRef]
- Aye, A.; Song, Y.J.; Jeon, Y.D.; Jin, J.S. Xanthone suppresses allergic contact dermatitis in vitro and in vivo. Int. Immunopharmacol. 2020, 78, 106061. [Google Scholar] [CrossRef]

Publisher’s Note: MDPI stays neutral with regard to jurisdictional claims in published maps and institutional affiliations. |
© 2022 by the authors. Licensee MDPI, Basel, Switzerland. This article is an open access article distributed under the terms and conditions of the Creative Commons Attribution (CC BY) license (https://creativecommons.org/licenses/by/4.0/).
Share and Cite
Yang, X.; Xiong, B.; Yuan, Z.; Liao, H.; Liu, X.; Wu, Y.; Zhang, S.; Xiang, Q. Polygalaxanthone III, an Active Ingredient in Polygala japonica Houtt., Repaired Malassezia-Stimulated Skin Injury via STAT3 Phosphorylated Activation. Molecules 2022, 27, 7520. https://doi.org/10.3390/molecules27217520
Yang X, Xiong B, Yuan Z, Liao H, Liu X, Wu Y, Zhang S, Xiang Q. Polygalaxanthone III, an Active Ingredient in Polygala japonica Houtt., Repaired Malassezia-Stimulated Skin Injury via STAT3 Phosphorylated Activation. Molecules. 2022; 27(21):7520. https://doi.org/10.3390/molecules27217520
Chicago/Turabian StyleYang, Xiaobin, Bei Xiong, Zhuolei Yuan, Hui Liao, Xiaowei Liu, Yinan Wu, Shu Zhang, and Qi Xiang. 2022. "Polygalaxanthone III, an Active Ingredient in Polygala japonica Houtt., Repaired Malassezia-Stimulated Skin Injury via STAT3 Phosphorylated Activation" Molecules 27, no. 21: 7520. https://doi.org/10.3390/molecules27217520
APA StyleYang, X., Xiong, B., Yuan, Z., Liao, H., Liu, X., Wu, Y., Zhang, S., & Xiang, Q. (2022). Polygalaxanthone III, an Active Ingredient in Polygala japonica Houtt., Repaired Malassezia-Stimulated Skin Injury via STAT3 Phosphorylated Activation. Molecules, 27(21), 7520. https://doi.org/10.3390/molecules27217520

